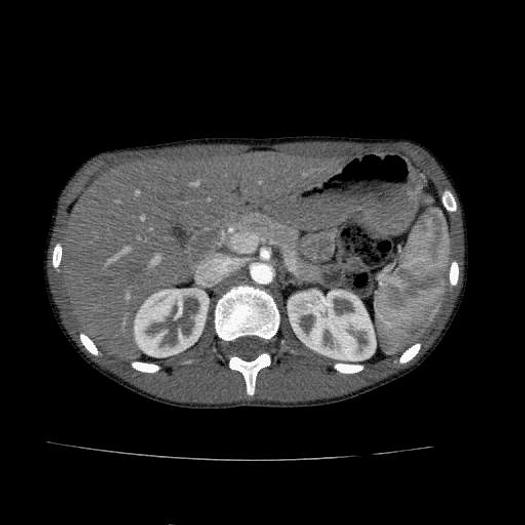
Reformado 2005 Toshiba Aquilion 64/120

2005 Toshiba Aquilion 64/120

2005 Toshiba Aquilion 64/120
o
Llamar +52 (81) 2940 7948
Descripción
Tomógrafo TOSHIBA Aquilion 64:
- 64 x 0.5 mm cortes
- Software de 120 cortes habilitado
- Reconstrucción doble de las imágenes
- La mejor resolución del mercado para estudios de cardiología
- Software avanzado para cardiología y neuro.
- Permite visualizar vasos sanguíneos con alta definición
- Reduce la dosis de radiación en los pacientes sin perder calidad de imagen
- Automáticamente se crean protocolos en base a la anatomía de los pacientes
- Permite reducir en un 40% las dosis de radiación a los pacientes en comparación con protocolos tradicionales
- Gracias a la velocidad de procesamiento de imagen se pueden procesar diferentes anatomías en una misma sesión sin necesidad de modificar el protocolo
- Protocolos pediátricos automáticos en base a la edad del paciente
- DICOM 3.0
- Reconstrucción de 28 imágenes por segundo
- Reconstrucciones en 2D y 3D
- Generador de 72 kW
- Tubo de rayos x año 2020
Especificaciones
| Fabricante | Toshiba |
| Modelo | Aquilion 64/120 |
| Año | 2005 |
| Condición | Reformado |
| Promedio de vida del Tubo de Rayos X: | 500,000 segundos |
| Año del tubo de Rayos X: | 2020 con 200,000 segundos |
| Alimentación V: | 480V |
| Requerimiento eléctrico (kVA): | 100 |